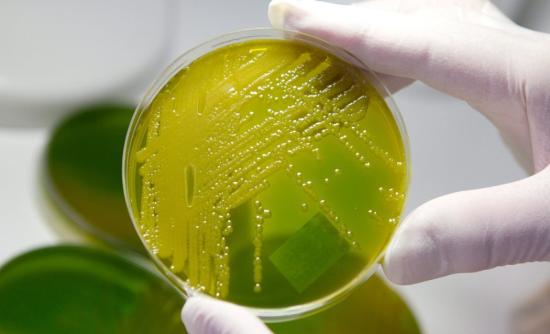

Το Ομοσπονδιακό Κέντρο Ελέγχου και Πρόληψης Ασθενειών των ΗΠΑ εξέδωσε προειδοποίηση για το ενδεχόμενο 10.000 άνθρωποι να έχουν έλθει σε επαφή με ένα θανατηφόρο ιό έπειτα από τη διαμονή τους στο Εθνικό Πάρκο Γιοσέμιτι της Καλιφόρνιας κατά τη διάρκεια του φετινού καλοκαιριού.Εχουν εντοπισθεί τουλάχιστον έξι κρούσματα του πνευμονικού συνδρόμου HPS που προκαλείται από στελέχη του ιού Hanta και προκαλεί οξύ πνευμονικό οίδημα. Ο ιός βρίσκεται στα εκκρίματα ενός είδους ποντικού και μεταδίδεται με την εισπνοή. Δύο από τους προσβληθέντες έχουν ήδη πεθάνει. Oλοι είχαν διαμείνει στο “Curry Village” του Εθνικού Πάρκου Γιοσέμιτι.Η υπηρεσία Εθνικών Πάρκων προσπάθησε να έλθει σε επαφή με τους 2.900 επισκέπτες που είχαν κάνει κρατήσεις για παραμονή στο κάμπινγκ του “Curry Village” ανάμεσα στις 10 Ιουνίου και τις 24 Αυγούστου. Η υπηρεσία υπολογίζει ότι συνολικά 10.000 άτομα διέμειναν στο διάστημα αυτό στο κάμπινγκ, τα 2.900 άτομα που έκαναν τις κρατήσεις μαζί με τα μέλη των οικογενειών τους και τους φίλους που τούς συνόδευαν.”Οι σκηνές απολυμάνθηκαν στις 24 Αυγούστου και το κάμπινγκ επαναλειτουργεί. Αλλά τα άτομα που διέμειναν κατά το διάστημα μεταξύ της 10ης Ιουνίου και της 24ης Αυγούστου διατρέχουν τον κίνδυνο να αναπτύξουν το σύνδρομο που έχει στάδιο επώασης έξι εβδομάδων”, αναφέρεται στην ανακοίνωση του Ομοσπονδιακού Κέντρου Ελέγχου και Πρόληψης Ασθενειών.Το σύνδρομο HPS είναι αρκετά σπάνιο, αλλά πολύ επικίνδυνο: το ποσοστό θνησιμότητας είναι πάνω από 30%. Εκδηλώνεται με ήπια συμπτώματα αρχικά, όπως πυρετό, κεφαλαλγίες, προβλήματα του πεπτικού, βήχα…αλλά σύντομα μπορεί να αποδειχθεί μοιραίο.Δεν υπάρχει θεραπεία, κατά συνέπεια η έγκαιρη νοσηλεία είναι απαραίτητη για την αύξηση της πιθανότητας επιβίωσης των ασθενών.Η ασθένεια εντοπίσθηκε στις ΗΠΑ το 1993. Έκτοτε έχουν διαγνωσθεί περί τα εξήντα κρούσματα στην Καλιφόρνια και 587 συνολικά στις ΗΠΑ. Περισσότεροι από το εν τρίτον των ασθενών κατέληξαν.
ΗΠΑ: Συναγερμός για ιό
Το Ομοσπονδιακό Κέντρο Ελέγχου και Πρόληψης Ασθενειών των ΗΠΑ εξέδωσε προειδοποίηση για το ενδεχόμενο 10.000 άνθρωποι να έχουν έλθει σε επαφή με ένα θανατηφόρο ιό έπειτα από τη διαμονή τους... ΔΙΑΒΑΣΤΕ ΕΔΩ
ΔΗΜΟΣΙΕΥΣΗ
Διεθνή Νέα
Google
Προσθέστε το ENIKOS ως προτιμώμενη πηγή στη Google
Google
Προσθέστε το ENIKOS στην Google
Ακολουθήστε το ENIKOS στο Google News και μάθετε πρώτοι όλες τις ειδήσεις.
ΔΙΑΦΗΜΙΣΗ